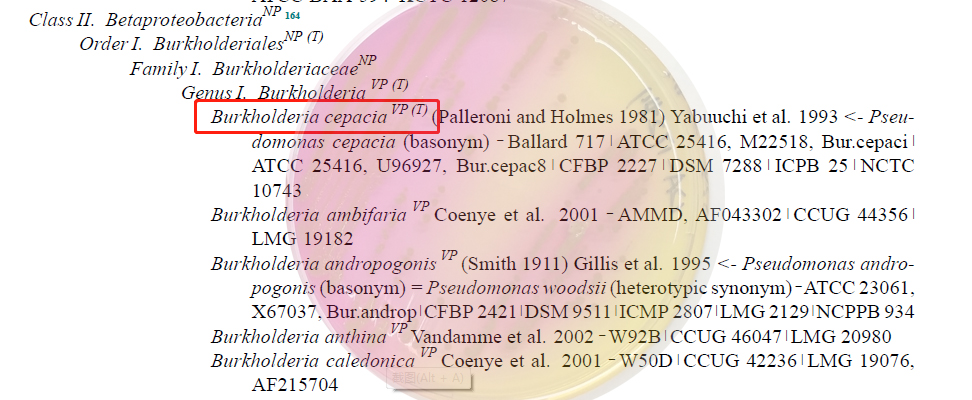

关于洋葱伯克霍尔德菌,你了解多少?
一. 背景
洋葱伯克霍尔德菌,拉丁名:Burkholderia cepacia (B. cepacia),原属假单胞菌属(Pseudomonas cepacia),是植物病原菌,因引起植物患病而得名,1971年首次有引起人类感染的报道。是囊性纤维化(CF)患者和慢性肉芽肿性病患者的条件致病菌。
参照PDA TR67中:“表2:与产品召回、非无菌制剂引起的感染及临床感染相关的常见微生物种类”,与洋葱伯克霍尔德菌有关的产品召回事件在所有召回事件中(N=144)占据首位(出现34 次),也占据着大众视野。该菌已经被美国FDA列为不可接受微生物。
二. 生长特性
(1) 洋葱伯克霍尔德菌为需氧非发酵菌,最适生长温度为30-35℃;革兰氏染色,在显微镜下观察,为革兰氏阴性无芽孢杆菌;
(2) 氧化酶试验:迟缓性氧化酶阳性(紫红色、紫色或者深蓝色),反应时间为2-10min;
(3) 过氧化氢酶试验:洋葱伯克霍尔德菌为迟缓产气,1s后缓慢出现气泡;
(4) 蔗糖氧化阳性;枸橼酸盐利用试验阳性;七叶苷利用阳性;
(5) 在药品检验用非选择性培养基中(TSA/TSB/SDA/SDB/NA/NB/R2A)能够生长良好,在选择性培养基麦康凯液体(MACB)、麦康凯琼脂(MACA)和紫红胆盐琼脂培养基(VRBGA)中能够生长良好。在CA上25℃培缓慢生长。EE里缓慢生长,RVS和XLD不支持该菌生长。
三. 相关检测标准
(1)《SN/T 4684-2016 进出口化妆品中洋葱伯克霍尔德菌检验方法》
该标准规定了进出口化妆品检验洋葱伯克霍尔德菌方法为:分别用含多粘菌素B的SCDLP增菌液和含庆大霉素的BCSA增菌液依次进行增菌培养,再分别在BCSA琼脂(含多粘菌素B和庆大霉素)和麦康凯琼脂(含多粘菌素B和庆大霉素)平板上进行分离培养;最后对疑似菌落进行鉴定。
(2)《SN/T 4485-2016 进出口口腔清洁类产品中洋葱伯克霍尔德菌检验方法》
该标准规定了进出口口腔清洁类产品中检验洋葱伯克霍尔德菌方法为:通过改良LETHEEN氏肉汤增菌培养,再划线接种在洋葱伯克霍尔德菌琼脂上进行分离培养,最后对疑似菌进行鉴定。
(3)USP42<60> MICROBIOLOGICAL EXAMINATION OF NONSTERILE PRODUCTS—TESTS FOR BURKHOLDERIA CEPACIA COMPLEX
USP42<60>规定了使用TSB对样品进行预培养,在BCSA上划线选择性培养。洋葱伯克霍尔德菌可能存在的指示特征为周围黄色的绿棕色菌落,或者周围粉红色的白色菌落。挑选可疑菌进行鉴定。
四. 关于BCSA培养基(USP)

其中酪胨和酵母提取物提供丰富的氮源,乳糖和蔗糖提供两种碳源,酚红指示剂,结晶紫、万古霉素抑制革兰氏阳性菌的生长,庆大霉素抑制部分革兰氏阴性菌的生长,多粘菌素B可抑制铜绿假单胞菌、肺炎克雷伯菌、鲍曼不动杆菌等菌的生长。
目前,北京三药针对洋葱伯克霍尔德菌的检验开发了两种培养基,洋葱伯克霍尔德菌选择性琼脂基础(符合USP)和BCC培养基基础以及对应的配套试剂。


原文链接:https://mp.weixin.qq.com/s/_EL3dIQpR05UdZk_OLQx0Q
